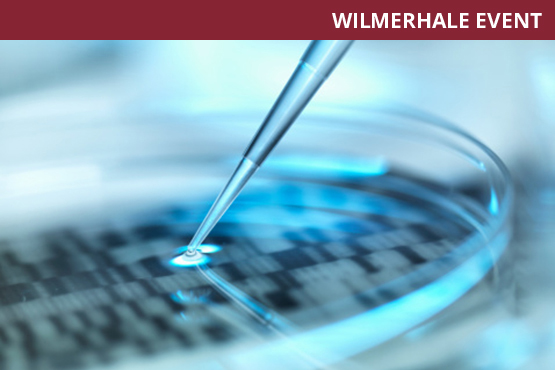
WilmerHale Legal Series for Biotech Founders: Getting Organized & Negotiating Your First Investment – Fundraising Through Convertible Debt

WilmerHale Legal Series for Biotech Founders: Getting Organized & Negotiating Your First Investment – Fundraising Through Convertible Debt
- 2.10.2014 - 2.11.2014
- Harlem Biospace 423 W 127th Street New York, New York 10027
Join the Harlem Biospace member companies and attorneys from our flagship partner WilmerHale for the third in a series of workshops on legal topics relevant to biotech ventures. This session is focused on fundraising through convertible debt, what it is and when it can be a better option than equity. We will explore how to recognize when such funding is appropriate to pursue and define important considerations for structuring a deal.
WilmerHale Partner Jennifer Berrent will lead the discussion and Senior Associate Jared DeMatteis will also participate.


